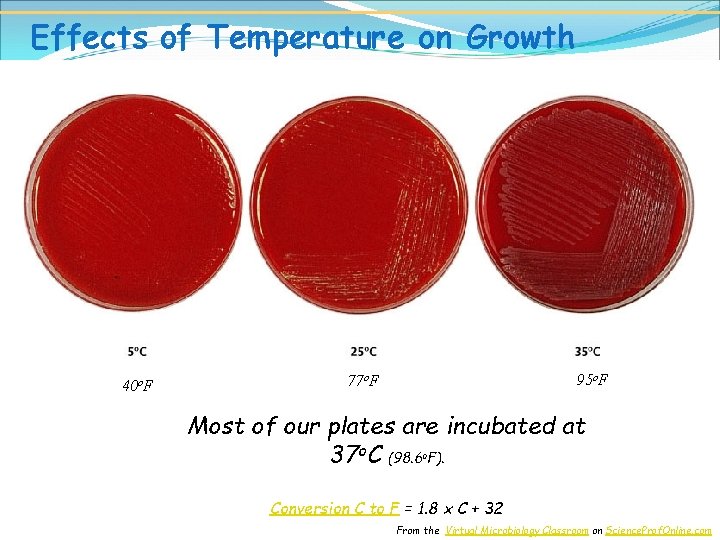
Effects of Temperature on Growth 40 o. F 95 o. F 77 o. F
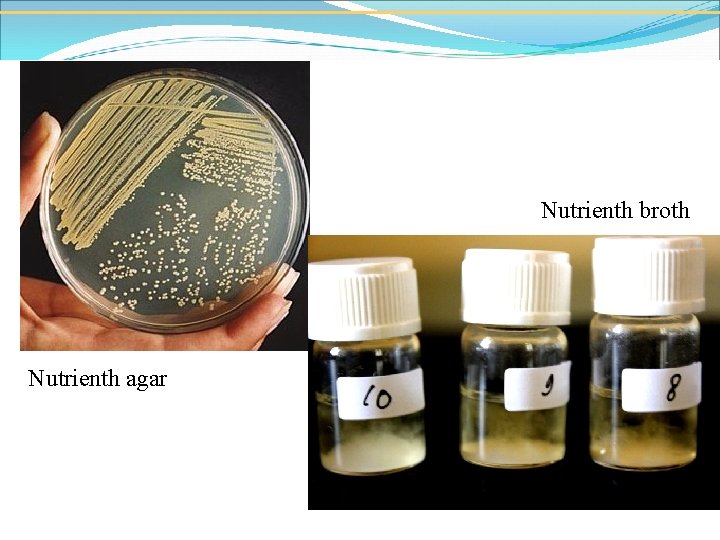
Nutrienth broth Nutrienth agar

Bacterial Growth drh Maxs U E Sanam M

Bacterial Growth drh. Maxs U. E. Sanam, M. Sc. Fakultas Kedokteran Hewan UNDANA

Growth of Bacteria How do bacteria grow? Measured as increase in cell number not size. Transverse binary fission or Binary Fission

Goals for Chapter What bacterial cells need to grow? How do we measure cell growth? What are the stages of cell growth? What is happening in cells during cell growth? What are the effects of environmental conditions on cell growth?

Cell division What is happening?

Microbial Growth Physical Requirements of Microbes Temperature (optimal enzyme operation) Psychrophiles, mesophiles, thermophiles p. H (optimal enzyme operation) Using buffers in media Molds & yeasts versus bacteria Chemical Requirements Carbon source in medium Nitrogen, sulfur, phosphorous, trace elements Oxygen requirements Obligate aerobes, anaerobes, facultative anaerobes Free radical oxygen (O 2 -) and H 2 O 2 dangers; superoxide dismutase and catalase = aerobes

Culture Media for Microbes Chemically defined vs. complex media Anaerobes: reducing media/Brewer jar Other: animals, eggs, tissue culture, CO 2 Media types Selective, Differential, Enrichment Bacterial Population Growth Curve: Lag, Log, Stationary, Death Quantifying Growth

Characterizing Microbes By Optimal Growth Temperature Figure 6. 1

Food Safety “ 2 -40 -140” If > 2 hrs at 40 -140 o. F, don’t eat it! Figure 6. 2
Effects of Temperature on Growth 40 o. F 95 o. F 77 o. F Most of our plates are incubated at 37 o. C (98. 6 F). o Conversion C to F = 1. 8 x C + 32 From the Virtual Microbiology Classroom on Science. Prof. Online. com

Alkalophiles Neutrophiles Acidophiles Physical Requirements: p. H • Most bacteria grow between p. H 6. 5 and 7. 5 • Molds and yeasts grow between p. H 5 and 6

Physical Requirements: Osmotic Pressure • Hypertonic environments, increase salt or sugar, cause plasmolysis • Extreme or obligate halophiles require high osmotic pressure • Facultative halophiles tolerate high osmotic pressure

Microbial Growth Physical Requirements of Microbes Temperature (optimal enzyme operation) Psychrophiles, mesophiles, thermophiles p. H (optimal enzyme operation) Using buffers in media Molds & yeasts versus bacteria Chemical Requirements Carbon source in medium Nitrogen, sulfur, phosphorous, trace elements Oxygen requirements Obligate aerobes, anaerobes, facultative anaerobes Free radical oxygen (O 2 -) and H 2 O 2 dangers; superoxide dismutase and catalase = aerobes

Culture Media for Microbes Chemically defined vs. complex media Anaerobes: reducing media/Brewer jar Other: animals, eggs, tissue culture, CO 2 Media types Selective, Differential, Enrichment Bacterial Population Growth Curve: Lag, Log, Stationary, Death Quantifying Growth

The Requirements for Growth: Chemical Requirements Carbon Structural organic molecules, energy source Chemoheterotrophs use organic carbon sources Autotrophs use CO 2

The Requirements for Growth: Chemical Requirements Nitrogen In amino acids, proteins Most bacteria decompose proteins Some bacteria use NH 4+ or NO 3 A few bacteria use N 2 in nitrogen fixation Sulfur In amino acids, thiamine, biotin Most bacteria decompose proteins Some bacteria use SO 42 or H 2 S Phosphorus In DNA, RNA, ATP, and membranes PO 43 is a source of phosphorus Trace Elements Inorganic elements required in small amounts Usually as enzyme cofactors

Microbial Growth Physical Requirements of Microbes Temperature (optimal enzyme operation) Psychrophiles, mesophiles, thermophiles p. H (optimal enzyme operation) Using buffers in media Molds & yeasts versus bacteria Chemical Requirements Carbon source in medium Nitrogen, sulfur, phosphorous, trace elements Oxygen requirements Obligate aerobes, anaerobes, facultative anaerobes Free radical oxygen (O 2 -) and H 2 O 2 dangers; superoxide dismutase and catalase = aerobes

Culture Media for Microbes Chemically defined vs. complex media Anaerobes: reducing media/Brewer jar Other: animals, eggs, tissue culture, CO 2 Media types Selective, Differential, Enrichment Bacterial Population Growth Curve: Lag, Log, Stationary, Death Quantifying Growth

How Toxic Forms of Oxygen Are Handled Singlet oxygen: O 2 boosted to a higher-energy state Handling superoxide free radicals: O 2 2 O 2 - + 8 H+ oxygen radicals 4 H 2 O 2 hydrogen peroxide Superoxide Dismutase (SODS) Handling peroxide anion: O 22 2 H 2 O 2 hydrogen peroxide 2 H 2 O + water Catalase (Peroxidase) Catalase Test: Bacteria + H 2 O 2 bubbles O 2 oxygen gas

Growth in thioglycollate broth reveals oxygen preferences Oxygen gradient Obligate aerobes Faultative anaerobes Obligate anaerobes Aerotolerant anaerobes Microaerophiles Resazurin dye is red in the presence of oxygen Thyoglycollate binds molecular oxygen, reducing it and removing it: R-SH + O 2 R-SO 2

Microbial Growth Physical Requirements of Microbes Temperature (optimal enzyme operation) Psychrophiles, mesophiles, thermophiles p. H (optimal enzyme operation) Using buffers in media Molds & yeasts versus bacteria Chemical Requirements Carbon source in medium Nitrogen, sulfur, phosphorous, trace elements Oxygen requirements Obligate aerobes, anaerobes, facultative anaerobes Free radical oxygen (O 2 -) and H 2 O 2 dangers; superoxide dismutase and catalase = aerobes

Culture Media for Microbes Chemically defined vs. complex media Anaerobes: reducing media/Brewer jar Other: animals, eggs, tissue culture, CO 2 Media types Selective, Differential, Enrichment Bacterial Population Growth Curve: Lag, Log, Stationary, Death Quantifying Growth

Culture Media: Chemically Defined or Complex Table 6. 2 & 6. 4

Anaerobic and Low O 2 Culture Methods Candle jar Brewer or anaerobic jar CO 2 packet

Unusual Culture Methods Grows only in certain cell types: using armadillos to culture M. leprae Grows only inside live cells: eggs as culture vessels for influenza virus Grows only in certain cell types: using tissue culture with low O 2, enriched CO 2 incubators

Microbial Growth Physical Requirements of Microbes Temperature (optimal enzyme operation) Psychrophiles, mesophiles, thermophiles p. H (optimal enzyme operation) Using buffers in media Molds & yeasts versus bacteria Chemical Requirements Carbon source in medium Nitrogen, sulfur, phosphorous, trace elements Oxygen requirements Obligate aerobes, anaerobes, facultative anaerobes Free radical oxygen (O 2 -) and H 2 O 2 dangers; superoxide dismutase and catalase = aerobes Culture Media for Microbes Chemically defined vs. complex media Anaerobes: reducing media/Brewer jar Other: animals, eggs, tissue culture, CO 2 Media types Selective, Differential, Enrichment Bacterial Population Growth Curve: Lag, Log, Stationary, Death Quantifying Growth
Nutrienth broth Nutrienth agar

Selective Media Goal: To chemically (or physically) suppress unwanted microbes and encourage desired microbes. MSA Mannitol salt agar : selective for halophiles with 7% salt (osmotic challenge) and differential for mannitol fermenters: good for skin bacterial cultures. EMB Agar: kills gram positives with eosin and methylene blue, selective for gram negatives. Differential for lactose fermenters. Good for growing enterics. Mc. Conkey Agar: supresses gram positives with crystal violet and bile salts; also differential for EMB MA Figure 6. 9 b, c

Differential Media Distinguish between different species based on a metabolic ability. Blood agar (sheep’s blood) reveals if hemolytic Mannitol salt agar contains the p. H sensitive dye phenol red (yellow when acidic) Se Sa Figure 6. 9 a

Hemolyses of Streptococcus spp. (left) α-hemolysis (S. mitis); (middle) βhemolysis (S. pyogenes); (right) γ-hemolysis (= non-hemolytic, S. salivarius)

On the left is a positive Staphylococcus infection, on the right a positive Streptococcus culture.

TSI Agar

Enrichment Media Encourages growth of desired microbe by providing special growth conditions or added growth factors Thioglycollate Anaerobic or Brewer Jar Lysed red blood cells provide unique nutrients in blood/chocolate agar Glucose Salts Agar (enriches for microbes that can growth only on glucose and some inorganic nutrients

Pure Cultures Used To Study Characteristics of a Particular Species A pure culture contains only one species or strain A colony is a population of cells arising from a single cell or spore or from a group of attached cells A colony is often called a colony-forming unit (CFU)

Microbial Growth Physical Requirements of Microbes Temperature (optimal enzyme operation) Psychrophiles, mesophiles, thermophiles p. H (optimal enzyme operation) Using buffers in media Molds & yeasts versus bacteria Chemical Requirements Carbon source in medium Nitrogen, sulfur, phosphorous, trace elements Oxygen requirements Obligate aerobes, anaerobes, facultative anaerobes Free radical oxygen (O 2 -) and H 2 O 2 dangers; superoxide dismutase and catalase = aerobes

Culture Media for Microbes Chemically defined vs. complex media Anaerobes: reducing media/Brewer jar Other: animals, eggs, tissue culture, CO 2 Media types Selective, Differential, Enrichment Bacterial Population Growth Curve: Lag, Log, Stationary, Death Quantifying Growth

Bacterial Growth is Exponential (Logarithmic) Bacterial “growth” means an increase in the number of individuals, not an increase in cell size. Figure 6. 12 b

Generation Number Cell Count 0 1 1 2 2 4 3 8 4 16 5 32 10 1, 024 20 1, 048, 576

Growth Curve for Bacteria (Logarithmic Plot) Figure 6. 14

Estimating Bacterial Numbers by Indirect methods Direct Measures Plate counts of viable bacterial forming colonies Counting low viable bacterial numbers by filtration Counting viable bacteria with Most Probable Number Counting bacteria per ml in direct microscopy Indirect Measures Turbidity/Absorbance with a spectrophotometer Metabolic activity tracking conversion of colored molecules Dry weight by weighing a set volume and knowing weight of one cell

Plate Assays: Spread Plate or Pour Plate Methods After incubation, count colonies on plates that have 30300 colonies (CFUs) The dilution in a particular tube = ml of fluid added to tube/total volume after addition; e. g. 1 ml/(9 ml + 1 ml) = 1/10 = 10 -2 Figure 6. 15

Direct Measurements of Microbial Growth Figure 6. 19

Direct Measurements of Microbial Growth Filtration: Good for measuring very dilute samples of bacteria Figure 6. 17 a, b

Direct Measurements of Microbial Growth Multiple tube MPN test Count positive tubes and compare to statistical MPN table Produces a range of concentrations Figure 6. 18 b

Indirect methods Direct Measures Plate counts of viable bacterial forming colonies Counting low viable bacterial numbers by filtration Counting viable bacteria with Most Probable Number Counting bacteria per ml in direct microscopy Indirect Measures Turbidity/Absorbance with a spectrophotometer Metabolic activity tracking conversion of colored molecules/enyzme assay Dry weight by weighing a set volume and knowing weight of one cell

Estimating Bacterial Numbers by Indirect Methods Turbidity Figure 620

Metabolic Conversion/Enzyme 1 bacterium produces 4. 6 x 10 NADH/sec/cell under Assay idea growth conditions. 12 In a 1 ml sample of growing cells, 5. 2 x 1023 NADH/sec/ml are produced per second (as revealed by a color-based assay of NADH on the sample) Therefore, (4. 6 x 1012 NADH/sec/ml) x (5. 2 x 1023 NADH/sec/cell) = 2. 3 x 1024 cells/ml

Determining dry mass of a fixed volume An E. coli cell has a dry mass of about 7. 0 x 10 -19 mg. A 1 ml sample with a dry mass of 2 mg therefore has: 2 mg/ml x 1 cell/7 x 10 -19 mg = 2. 8 x 1020 cells/ml
- Slides: 47